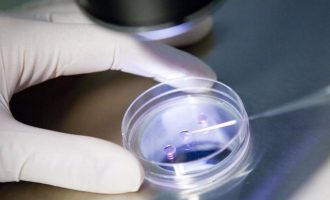

Έρευνα: Ο κορωνοϊός δεν ανιχνεύεται στο ανθρώπινο σπέρμα
Αμερικανοί επιστήμονες και ερευνητές της Cryos International Sperm & Egg Bank, διεθνούς τράπεζας σπέρματος και ωαρίων με έδρα τη Δανία…
Περισσότερα »
Εντοπίστηκε κορωνοϊός στο σπέρμα ασθενών – Τι λένε Κινέζοι ερευνητές
Κινέζοι ερευνητές που εξέτασαν σπερματοζωάρια ανδρών οι οποίοι είχαν προσβληθεί από την ασθένεια Covid-19, διαπίστωσαν ότι μια μικρή μειοψηφία από…
Περισσότερα »
Γιατρός έδινε για δεκαετίες το δικό του σπέρμα στις εξωσωματικές
Γιατρός που ειδικεύονταν στην εξωσωματική γονιμοποίηση χρησιμοποιούσε το… δικό του σπέρμα και όχι των δωρητών και των συζύγων. Ο γιατρός…
Περισσότερα »
Γονιμοποίησαν πρόβατα με το παλαιότερο σπέρμα στον κόσμο
Επιστήμονες στην Αυστραλία κατόρθωσαν να γονιμοποιήσουν πρόβατα, χρησιμοποιώντας σπέρμα κατεψυγμένο επί 50 χρόνια! Το σπέρμα είχε αποθηκευθεί το 1968 σε…
Περισσότερα »
Σπάνια δίδυμα γεννήθηκαν από ένα ωάριο και δύο σπερματοζωάρια
Τη δεύτερη γνωστή περίπτωση στον κόσμο της γέννησης ημι-πανομοιότυπων διδύμων από ένα ωάριο και δύο σπερματοζωάρια, επιβεβαίωσαν γιατροί στην Αυστραλία….
Περισσότερα »
Τα σπερματοζωάρια των ανδρών που καπνίζουν μαριχουάνα κάνουν… κύκλους και δεν βρίσκουν… στόχο
Άνθρωποι που καπνίζουν πάρα πολλή μαριχουάνα θα μπορούσαν να αντιμετωπίσουν προβλήματα γονιμότητας, επειδή τα ναρκωτικά κάνουν το σπέρμα «μαλακό» ωθώντας…
Περισσότερα »
Η ποσότητα του ανδρικού σπέρματος στη Δύση μειώθηκε κατά 60% – Καμία μείωση στην Ανατολή
Οι αλλαγές στο περιβάλλον, το στρες από τον φρενήρη ρυθμό ζωής, η μόλυνση του αέρα, οι «πλαστικές» τροφές και η…
Περισσότερα »
Μάνα ήθελε να γονιμοποιήσει την 17χρονη κόρη της με το σπέρμα του συντρόφου της
Μία γυναίκα στις Ηνωμένες Πολιτείες, προσπάθησε να γονιμοποιήσει τη 17χρονη κόρη της, χρησιμοποιώντας ένα όργανο για τη γέμιση γαλοπούλας και…
Περισσότερα »
Κλινική στην Ολλανδία γονιμοποίησε 26 γυναίκες με λάθος σπέρμα
Ενα επαναλαμβανόμενο διαδικαστικό σφάλμα σε κλινική θεραπείας υπογονιμότητας, οδήγησε πιθανόν στη γονιμοποίηση ωαρίων 26 γυναικών με λάθος σπέρμα. Από τα…
Περισσότερα »
Απίστευτο: Γεννήθηκε παιδί από τρεις γονείς!
Γεννήθηκε στο Μεξικό από Αμερικανούς επιστήμονες το πρώτο στον κόσμο παιδί με τρεις γενετικούς γονείς, καθώς εκτός από το DNA…
Περισσότερα »
Η Κίνα συμβουλεύει τους άνδρες: Χρειαζόμαστε το σπέρμα σας!
Δεν έχει περάσει πολύς καιρός από τότε που στην Κίνα επιτρεπόταν η γέννηση ενός μόλις παιδιού ανά ζευγάρι, λόγω του…
Περισσότερα »
Απολιθωμένο σπερματοζωάριο “γίγας” ανακαλύφθηκε στην Αυστραλία
Ένα απολιθωμένο σπερματοζωάριο “γιγαντιαίων” διαστάσεων ανακάλυψαν επιστήμονες στην Αυστραλία, ηλικίας τουλάχιστον 16 εκατ. ετών (ίσως και 23 εκατ. ετών), το…
Περισσότερα »
Έφτιαξαν σπερματοζωάρια από… δέρμα
Mια νέα επιστημονική ανακάλυψη δίνει ελπίδα σε εκατομμύρια άνδρες ανά τον κόσμο που αντιμετωπίζουν προβλήματα με το σπέρμα τους και…
Περισσότερα »